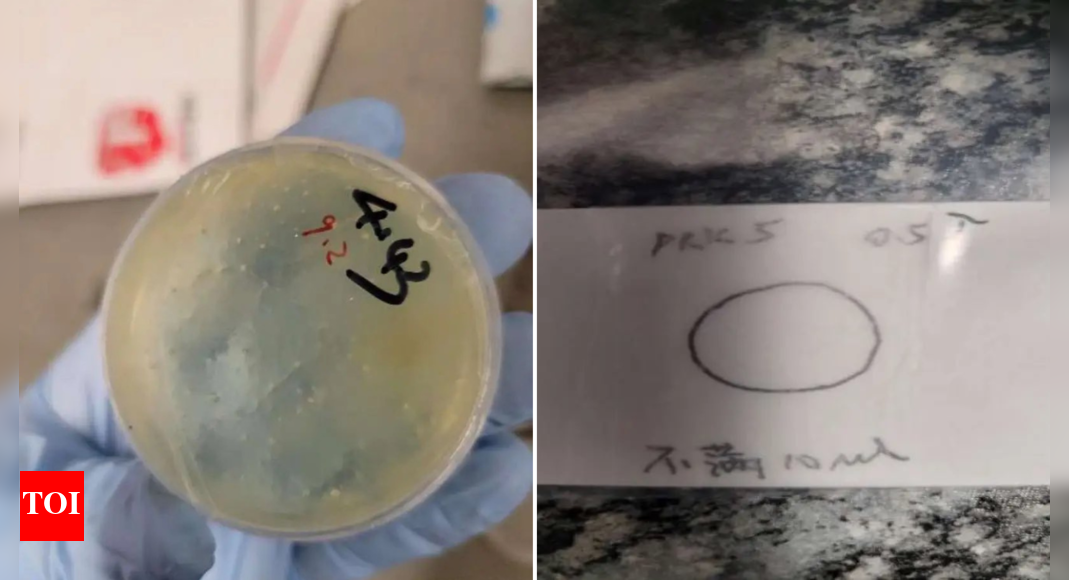

Health Secretary Robert F. Kennedy Jr. on Monday (June 9, 2025) eliminated each member of a scientific committee that advises the Centers for Disease Control and Prevention on the way to use vaccines and pledged to interchange them together with his personal picks.
The 17-member Advisory Committee on Immunization Practices had been in a state of flux since Kennedy took over. Its first assembly this yr had been delayed when the U.S. Department of Health and Human Services abruptly postponed its February assembly.
Mr Kennedy, who was one of many nation’s main anti-vaccine activists earlier than turning into the nation’s high well being official, just lately took the weird step of adjusting COVID-19 suggestions with out first consulting the panel.
Mr Kennedy, in a Wall Street Journal opinion piece, mentioned the committee members had too many conflicts of curiosity. Committee members routinely disclose any attainable conflicts at the beginning of public conferences.
Published – June 10, 2025 03:05 am IST